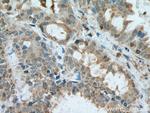
VAMP5 Antibody in Immunohistochemistry (Paraffin) (IHC (P))

Search
Proteintech
VAMP5 Polyclonal Antibody
{{$productOrderCtrl.translations['antibody.pdp.commerceCard.promotion.promotions']}}
{{$productOrderCtrl.translations['antibody.pdp.commerceCard.promotion.viewpromo']}}
{{$productOrderCtrl.translations['antibody.pdp.commerceCard.promotion.promocode']}}: {{promo.promoCode}} {{promo.promoTitle}} {{promo.promoDescription}}. {{$productOrderCtrl.translations['antibody.pdp.commerceCard.promotion.learnmore']}}
产品信息
11822-1-AP
种属反应
宿主/亚型
分类
类型
抗原
偶联物
形式
浓度
规格
纯化类型
保存液
内含物
保存条件
运输条件
产品详细信息
Immunogen sequence: MAGIELERC QQQANEVTEI MRNNFGKVLE RGVKLAELQQ RSDQLLDMSS TFNKTTQNLA QKKCWENIRY RICVGLVVVG VLLIILIVLL VVFLPQSSDS SSAPRTQDAG IASGPGN (1-116 aa encoded by BC017891)
靶标信息
Synaptobrevins/VAMPs, syntaxins, and the 25-kD synaptosomal-associated protein are the main components of a protein complex involved in the docking and/or fusion of vesicles and cell membranes. The VAMP5 gene is a member of the vesicle-associated membrane protein (VAMP)/synaptobrevin family and the SNARE superfamily. This VAMP family member may participate in vesicle trafficking events that are associated with myogenesis.
仅用于科研。不用于诊断过程。未经明确授权不得转售。
生物信息学
蛋白别名: Myobrevin; unnamed protein product; vamp; VAMP-5; VAMP5; Vesicle-associated membrane protein 5
基因别名: AF119384; Camp; HSPC191; VAMP5
UniProt ID: (Human) O95183, (Mouse) Q9Z2P8, (Rat) Q9Z2J5
Entrez Gene ID: (Human) 10791, (Mouse) 53620, (Rat) 89818